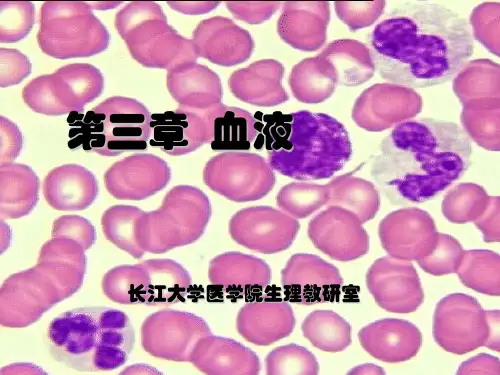

压力 大(300mmol/L或770KPa) 小(1.3mmol/L或 3.3KPa)
意义 维持细胞内外水分交换 调节毛细血管内外水分
保持RBC正常形态和功能 的交换和维持血浆容量
精选ppt
17
思考:如大量丢失白蛋白,会出现什么情 况?
精选ppt
18
几个概念
等渗溶液——渗透压与血浆渗透压相等的溶液。如
② 影响因素:
遗传性球形细胞增多症
☻表面积与体积的比值:比值大,易变形。 ☻胞内容物粘度: Hb浓度↑→粘度↑→变形能力↓ ☻ 红细胞膜弹性: 弹性大,变形能力大
RBC
通 过 脾 窦 的 过 程
1. 未成熟的RBC变性能力差,难以通过骨髓血窦, 不易进入血液循环。
2. 衰老和异常的RBC难以通过脾窦而被清除
诊断:甲型血友病
问题与思考:
为何患儿有经常出血的现象,但血小板计数,出 血时间,血块收缩正常?
患儿有经常出血的现象与凝血时间延长,血浆 凝血因子VIII活性极低有何关系?
你考虑患儿患有何种血液疾病?你的诊断依据 是什么?
精选ppt
3
血液是内环境中最活跃的部分
血液的功能
1、运输功能 2、缓冲功能 3、维持体温相对稳定 4、参与生理性止血和机体的防御机能
精选ppt
12
3 晶体渗透压(crystal osmotic pressure)
构成: 由血浆中的晶体物质所形成的渗透压,主要来自血浆中
的Na+和Cl-。
作用:维持细胞内外的水平衡,保持细胞的正常体积、形态和
功能。
精选ppt
13
血浆液晶渗压↓ 引起 细胞肿胀
血浆液晶渗压↑ 引起 细胞皱缩






![生理学3血液[可修改版ppt]](https://uimg.taocdn.com/bd8dacf1af45b307e97197b3.webp)